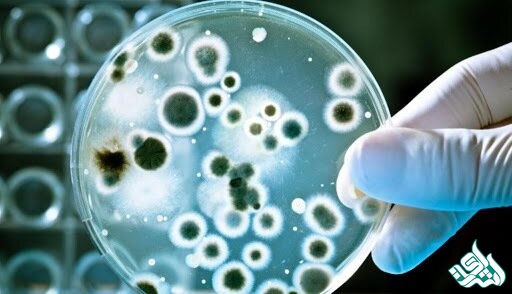
زیست فناوری میکروبی

ویرایش متون رشته زیست فناوری میکروبی
شبکه مترجمین اشراق: متون رشته زیستفناوری میکروبی از اهمیت بالایی برخوردار است. به دلیل تخصصی بودن این رشته ویرایش متون چنین رشتههایی باید بهصورت تخصصی ویراستاری شود ویرایش متون رشته زیستفناوری میکروبی باید از جهات گوناگونی مانند محتوا، بیان، صحت و اعتبار، دقت، نظم، آراستگی و علائم نگارشی بررسی و بازبینی شود تا متنی تخصصی و علمی به دست آید.

فناوری میکروبی چیست؟
شرح فناوری میکروبی: فرآیندهای میکروبی ، تولید و کاربردهای باکتریها، مخمرها ، قالبها و ویروسها را توصیف می کند و فناوریهای مرتبط با محصولات متابولیسم میکروبی را بررسی می کند.
مدل میکروبی چیست؟
در مدل سازی میکروبی ، از مدل های ریاضی برای پیش بینی رشد یا بقای میکروارگانیسم ها در مواد غذایی استفاده می شود. مدل ها با مطالعه رشد یا بقای میکروارگانیسم ها در طی یک دوره تحت شرایط مشخص ذخیره سازی تولید می شوند.
ایمنی میکروبی چیست؟
آزمایشگاه میکروبیولوژیکی یک محیط منحصر به فرد است که به منظور محافظت صحیح از افرادی که با میکروارگانیسم ها کار می کنند ، نیاز به اقدامات ویژه و امکانات مهار دارد. میکروبیولوژیکی علمی طیف وسیعی از محصولات تست ایمنی را ارائه می دهد که همگی به ایمنی در آزمایشگاه اختصاص داده شده اند.
نمونه ای از خطر میکروبی چیست؟
خطر میکروبیولوژیکی هنگامی ایجاد می شود که مواد غذایی توسط میکروارگانیسم های موجود در هوا ، غذا ، آب ، خاک ، حیوانات و بدن انسان آلوده شوند. بسیاری از میکروارگانیسم ها برای خود زندگی مفید و ضروری هستند. … میکروارگانیسم هایی که معمولاً با بیماری های ناشی از غذا ارتباط دارند شامل باکتری ها ، ویروس ها و انگل ها هستند.
آیا سالمونلا یک خطر میکروبی است؟
به طور کلی شناخته شده است که مهمترین خطرات ناشی از مواد غذایی از گوشت تازه ، باکتری هایی هستند که می توانند باعث ایجاد بیماری در انسان شوند (باکتری های بیماری زا) ، مانند سالمونلا ، کامپیلوباکتر و E. coli بیماری زا انسانی مانند E. coli O157.
بیوتکنولوژی میکروبی چیست؟
بیوتکنولوژی میکروبی یا میکروبیولوژی صنعتی استفاده از میکروارگانیسم ها برای به دست آوردن یک محصول یا فعالیت با ارزش اقتصادی در مقیاس تجاری یا بزرگ است. میکروارگانیسم هایی که در فرآیندهای صنعتی مورد استفاده قرار می گیرند ، سویه های جهش یافته طبیعی یا آزمایشگاهی هستند
عوامل میکروبیولوژیکی چیست؟
میکروارگانیسم هایی با توجه به اینکه آلرژی زا وعفونی هستند یا قادر به ایجاد واکنش های سمی یا التهابی هنگام استنشاق هستند ، طبقه بندی می شوند. نمونه های نماینده از هر یک از این دسته ها ، که شامل باکتری ها ، قارچ ها ، ریکتسی و آمیب است ، بحث شده است.
هدف از آزمایش میکروبیولوژیکی چیست؟
هدف از آزمایش میکروبیولوژیکی باید شناسایی و محدود کردن میکروارگانیسم های مضر ، که می توانند غذاها را خراب کنند ، و ایمنی در برابر بیماری های ناشی از مواد غذایی باشد.
اهمیت آزمایش میکروبیولوژیکی مواد غذایی چیست؟
آنها می توانند مواد غذایی را خراب کنند ، سموم را معرفی کنند ، باعث بیماری شوند و منجر به مشکلات دیگری شوند. اهمیت آزمایش میکروبیولوژیکی شناسایی سریع این آلاینده ها و درمان آنها قبل از آسیب های جبران ناپذیر است.
میکروارگانیسم ها چگونه شناسایی می شوند؟
میکروارگانیسم ها با چشم غیر مسلح دیده نمی شوند ، بنابراین آنها به چندین روش غیرمستقیم شناسایی می شوند: میکروسکوپ برای شناسایی شکل سلول یا ظاهر اسپور. ... ظاهر مستعمرات در رسانه های آزمایشگاهی روشی گسترده است برای تمایز بین میکروب های مختلف ، به طور عمده باکتری ها.

کیفیت میکروبیولوژیکی چیست؟
مواد غذایی آلوده به میکروارگانیسم ها (باکتری ها و مخمرها) ، ویروس ها و تک یاخته ها می توانند رشد میکروارگانیسم ها در بدن پس از خوردن غذای آلوده باعث بیماری شدید در انسان شوند. به عنوان مثال. سالمونلا
ویرایش متون رشته زیست فناوری میکروبی
متون رشته زیستفناوری میکربی از اهمیت بالایی برخوردار است. به دلیل تخصصی بودن این رشته ویرایش متون چنین رشتههایی باید بهصورت تخصصی ویراستاری شود ویرایش متون رشته زیستفناوری میکربی باید از جهات گوناگونی مانند محتوا، بیان، صحت و اعتبار، دقت، نظم، آراستگی و علائم نگارشی بررسی و بازبینی شود تا متنی تخصصی و علمی به دست آید.
ویرایش متون رشته زیست فناوری میکروبی در شبکه مترجمین اشراق
ویرایش متون علمی در شبکه مترجمین اشراق توسط ویراستاران حرفهای و متخصص انجام میشود ویراستاران با ویرایش، نکات دستوری، کاربرد صحیح زمان افعال در بخشهای مختلف متون را جهت چاپ و نشر آماده میکنند.














